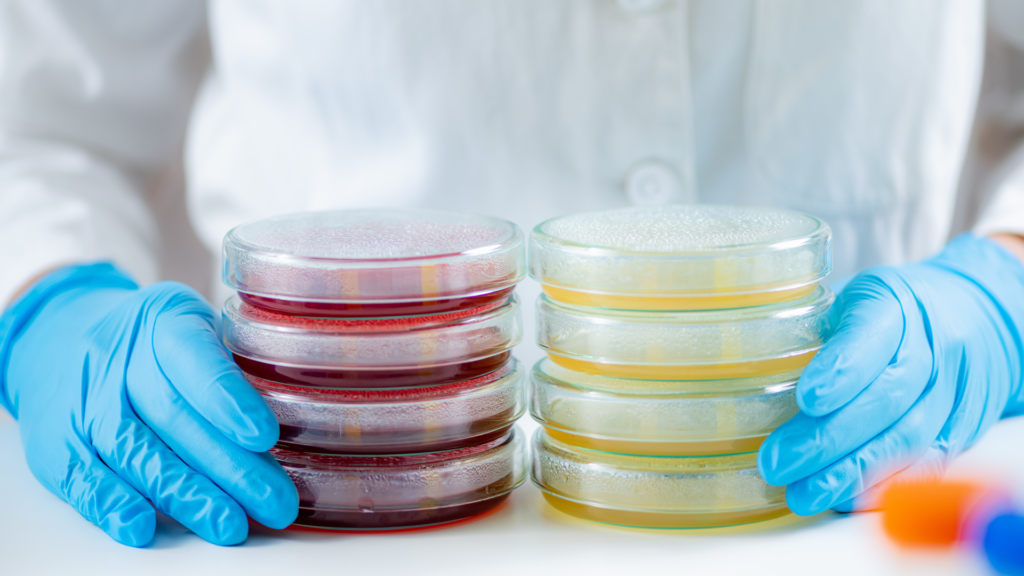

Success Stories
Value-Added Support and Logistic Expertise Proved the Winning Dish in Vietnam
By taking the extra steps to safeguard its customer’s products, DKSH managed to win over the trust of a leading confectionery and snacks manufacturer in Vietnam.
Related Insights

Singapore Food Retailer Becomes Bestseller With Innovative Approach

Strategic Field Activation Services Boost Brand Visibility for Econsave

Protecting the Environment Through Advanced Volatile Organic Compounds Analysis

Winning Retail Partnership with Rising Supermarket Brand in Singapore
Contact Us